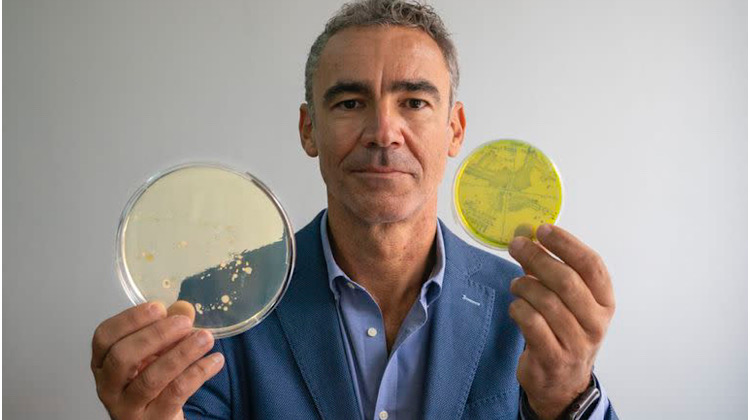

yahoo.com
MADRID.- El estudio madrileño en el que se rodó la película Mujeres al borde de un ataque de nervios se encuentra a solo unos metros del despacho de Cristina Muñoz, pero ella no parece nerviosa, pese a que lo suyo no es una comedia, sino más bien el guion de una película de terror.
Muñoz es la codirectora del Plan Nacional frente a la Resistencia a los Antibióticos, la iniciativa española para intentar frenar una de las mayores amenazas para la humanidad. Los medicamentos contra las bacterias están dejando de funcionar, a una velocidad ahora acelerada por el consumo excesivo e incorrecto durante la pandemia de Covid. La científica invita a imaginar el día a día sin antibióticos, un espeluznante mundo en el que cualquier infección podría ser letal. Sin cesáreas, sin trasplantes de órganos, sin operaciones de menisco, sin prótesis de cadera.
“Sería dar un paso atrás de casi 100 años en los avances médicos”, advierte Muñoz. “Pasarían cosas que ni se nos ocurre pensar, como que se caiga un niño, se abra la rodilla, lo lleves al hospital y el médico te diga que no hay nada que hacer, que lo siente mucho”, explica. Algunas enfermedades bacterianas —como la neumonía, la tuberculosis, la gonorrea y la salmonelosis— ya se están quedando sin tratamientos eficaces. La quimioterapia, que favorece las infecciones microbianas en los enfermos de cáncer al bajar sus defensas, también sería una práctica de alto riesgo en ausencia de antibióticos. “Dejaríamos de curar a las personas, pero también a los animales. No podríamos producir alimentos sanos”, advierte Muñoz. Al regreso de las enfermedades del siglo XIX habría que sumar las hambrunas.
Este 18 de noviembre comienza la Semana mundial de concienciación sobre el uso de los antimicrobianos y las autoridades tocan las trompetas del apocalipsis. Un informe elaborado para el Gobierno británico alertaba en 2016 de que los microbios resistentes a los fármacos —sobre todo las bacterias— ya mataban a 700.000 personas cada año en el planeta y de que se podría llegar a 10 millones de fallecimientos en 2050, más que los causados por el cáncer. El microbiólogo Bruno González Zorn alerta de que el covid ha empeorado la pandemia silenciosa de las superbacterias. “Puede que los 10 millones de muertes ya no ocurran en 2050, sino en 2040 o en 2030″, advierte.
Las bacterias se multiplican cada 20 minutos y a veces sufren mutaciones que son, por casualidad, un escudo frente a algún antibiótico. Y lo más inquietante es que pueden transmitir esos nuevos genes de resistencia a otras bacterias cercanas, incluso de otras familias. “Es como si yo aprendo alemán y te transmito a ti la capacidad”, explica González Zorn, catedrático de la Facultad de Veterinaria de la Universidad Complutense de Madrid. Cuantos más antibióticos se usan, más evolucionan las bacterias para resistir a ellos.

González Zorn afirma que se está formando “una tormenta perfecta” cy muestra los datos de los hospitales españoles durante la primera ola de ovid. De febrero a marzo de 2020 aumentó un 400% el uso de azitromicina, un antibiótico usado a la desesperada por si también funcionaba contra el virus SARS-CoV-2. El consumo de doxiciclina se incrementó un 517%. En España, estos niveles volvieron rápidamente a la normalidad, pero siguieron desbocados en otras regiones del mundo, como América Latina. “Durante la pandemia se han utilizado tantas carbapenemas [un tipo de antibióticos] que en algunos países, como Chile, tenemos los niveles de resistencia que esperábamos tener en 2030. Hemos acelerado 10 años. Estamos muy alarmados”, señala el investigador.
El microbiólogo es uno de los 15 miembros de un grupo internacional de científicos recién creado por la Organización Mundial de la Salud (OMS) para identificar qué antibióticos son esenciales para la salud humana, con el objetivo de blindar su uso para que sigan funcionando. Estos fármacos son como el Grupo Especial de Operaciones (GEO), la unidad de élite de la Policía Nacional. Si se necesitan y no funcionan, después de ellos no hay nada. Son el último recurso. Y las carbapenemas son precisamente una de estas últimas balas.
La oficina europea de la OMS lanzó una alerta en febrero: “No permitamos que la crisis de Covid se convierta en una catástrofe de resistencia a los antimicrobianos”. En algunos países, el escenario es escalofriante. Médicos del Hospital Almenara de Lima han advertido del uso “irracional e indiscriminado” de antimicrobianos en Perú durante la pandemia. Expertos en Estados Unidos, India, México y otros países también han hecho sonar las alarmas.
La microbióloga Ana Maria de Roda Husman, holandesa de padre español, advierte de que los mecanismos de resistencia, en principio, solo tienen que aparecer una vez. “Entonces la caja de Pandora ya está abierta”, señala. Su equipo, del Instituto Nacional para la Salud Pública de Países Bajos, ha detectado bacterias resistentes a carbapenemas por doquier en las aguas residuales del país. Las tuberías de los hospitales, y también las de los hogares, contribuyen a diseminar superbacterias en la naturaleza. La amenaza de combinaciones inimaginables está sobre la mesa.
Antibióticos en el agua
De Roda Husman alerta de que “los propios fabricantes de antibióticos pueden ser un problema, especialmente en regiones donde no existen leyes de residuos”. La investigadora cita la contaminación producida por una fábrica de azitromicina a unos 25 kilómetros de Zagreb, en Croacia, en el río Sava, ya colonizado por una rica comunidad de bacterias resistentes a antibióticos. En otros países, como la India, la gravedad de la situación se dispara. En 2007, un estudio halló niveles inauditos de antibióticos en las aguas vertidas en el río Isakavagu por una planta de tratamiento que da servicio a 90 fabricantes de medicamentos genéricos en Patancheru, una zona industrial cercana a la ciudad india de Hyderabad. La concentración del antibiótico ciprofloxacino en el río alcanzaba los 31 miligramos por litro, una dosis mil veces superior al umbral tóxico para algunas bacterias.
El microbiólogo clínico Rafael Cantón recuerda cuando empezó a trabajar, en 1988, y hacía pruebas de laboratorio para determinar la susceptibilidad de una bacteria a diferentes antibióticos. “Antes lo habitual era ver todo S, la letra inicial de sensible. Ahora la mayoría de los valores son R, de resistente. Solemos estudiar unos 20 antibióticos [para cada infección] y unas 15 veces al año nos encontramos con una situación dramática: todo R. No tenemos opciones terapéuticas para estos casos”, lamenta Cantón, jefe de Microbiología del Hospital Ramón y Cajal, en Madrid.
Las autoridades europeas calculan que las superbacterias ya matan cada año a 33.000 personas en el continente. La Agencia Española de Medicamentos y Productos Sanitarios, donde trabaja Cristina Muñoz, habla de unas 4000 muertes en España, el triple que las causadas por los accidentes de tráfico. Pese a las alertas, el último Eurobarómetro mostraba que el 42% de los españoles había tomado antibióticos en 2018, frente al 32% del total de la UE. Uno de cada tres encuestados en España pensaba, equivocadamente, que los antibióticos curan los resfriados, cuando en realidad están provocados por virus, no por bacterias.
Pandemia invisible
Rafael Cantón lamenta que, pese a estas cifras, la pandemia de supermicrobios sea prácticamente invisible. “No hay colectivos de pacientes que se quejen de la resistencia a antibióticos”, afirma. Es un silencio sorprendente, porque el 6% de los ingresados en los hospitales adquieren una infección en el propio centro, tras intervenciones como la colocación de una sonda urinaria o la intubación para la respiración artificial, según un estudio promovido por la Sociedad Española de Medicina Preventiva, Salud Pública e Higiene.
“Hay menos infecciones adquiridas en los hospitales, la mitad que en 1990, pero las que se adquieren ahora son más problemáticas”, advierte Cantón. “Lo llamamos capitalismo genético. Una bacteria que es resistente tiende a permanecer y tiene más posibilidades de adquirir todavía más mecanismos de resistencia. Es como el que ya tiene dinero, que tiene mayor facilidad para ganar más dinero”, expone.
El experto reconoce el “pico tremendo” de consumo de antibióticos en los hospitales durante la primera ola de la pandemia. “Eso nos ha recrudecido problemas que ya teníamos y han aparecido otros”, apunta Cantón en referencia a la proliferación de bacterias resistentes a las carbapenemas. “Han aumentado en todos los hospitales por el efecto selectivo de la utilización de antibióticos”, sostiene.
El panorama en la industria farmacéutica es desolador. Solo hay 43 antibióticos experimentales en ensayos clínicos, según la OMS, frente a más de 5700 posibles nuevos tratamientos contra el cáncer. Para el microbiólogo Marc Lemonnier, es un escándalo. “Por cada producto antibacteriano en desarrollo tienes más de 100 en oncología. Es inaceptable. Estamos hablando de una necesidad médica comparable. De aquí a 2050 estas infecciones matarán igual que el cáncer”, opina.
“Nadie quiere invertir”
Lemonnier, un hispanofrancés nacido en Tánger (Marruecos) hace 54 años y criado en Madrid, trabajó como científico hasta que en 2009 montó su propia empresa farmacéutica: Antabio. El nombre hace referencia a Anteo, el gigante norteafricano que, según la mitología griega, ganaba todas sus peleas, porque cada vez que caía al suelo obtenía nuevas fuerzas de su madre, Gea, la diosa de la tierra. “Hércules encontró una manera innovadora de matar a ese monstruo: levantarlo del suelo, para que no entrase en contacto con su madre. Y esa es exactamente la estrategia de mi empresa: encontrar una manera novedosa de matar a bacterias a las que nada puede matar”, señala Lemonnier. Un óleo de Zurbarán representa esta pelea de Anteo y Hércules en el Museo del Prado.
“La cantidad de antibióticos en desarrollo es paupérrima porque nadie quiere invertir en esta área”, sentencia el empresario. Las farmacéuticas ganaron más de 7000 millones de euros con productos contra el cáncer entre 2014 y 2016, al mismo tiempo que perdían unos 90 millones con los antibióticos, según la organización estadounidense Pew. El dinero ha volado a la oncología. En 2019, la inversión privada en potenciales tratamientos contra el cáncer rondó los 8600 millones de euros, frente a los 120 millones en antibióticos. “La paradoja es que es un área prioritaria para la OMS, pero absolutamente no prioritaria para los inversores privados”, lamenta Lemonnier.
El empresario ha logrado 44 millones de euros de financiación desde 2009 para el desarrollo de tres antibióticos prometedores. La mitad del dinero le ha llegado de organizaciones sin ánimo de lucro, como la británica Wellcome Trust y la estadounidense CARB-X. “Cada vez me es más complicado financiar mi empresa. Para mis estudios clínicos en humanos necesito levantar ahora decenas de millones, pero la inversión privada se está enrareciendo porque los inversores no ven salidas, no ven éxitos comerciales, y se van a otro sitio”, explica.
Grandes farmacéuticas —como la suiza Novartis, la británica AstraZeneca y la francesa Sanofi— han abandonado en los últimos años la investigación de nuevos antibióticos. “Si no cambia la dinámica, tenemos un problema mayúsculo. Estamos en una encrucijada que puede dar paso a una segunda pandemia mundial devastadora”, advierte Lemonnier, miembro de la junta directiva de BEAM, una alianza de 70 pequeñas y medianas empresas biotecnológicas europeas dedicadas a buscar tratamientos contra los microbios.
Una economista española, Laura Marín, dirige desde 2013 en Estocolmo la mayor iniciativa mundial de investigación de las resistencias antimicrobianas, el programa JPIAMR, con casi una treintena de países a bordo, como Alemania, España, India y la Argentina. “No hay un modelo de negocio favorable”, explica. “Crear nuevos antibióticos es complicado científicamente y todo el mundo ha dejado de hacerlo. El antibiótico luego se vende por un euro, así que no les sale a cuenta. Y si logramos un nuevo antibiótico no se lo vamos a querer dar a nadie, para reservarlo para los casos más graves, así que se van a vender muy pocos”, argumenta Marín. Hacen falta, subraya, incentivos económicos para las farmacéuticas y mucho más dinero público.
El programa JPIAMR intenta convencer a los países para que inviertan más cuanto antes, no solo para el desarrollo de nuevos antibióticos, sino para averiguar cómo mantener la eficacia de los que todavía funcionan. “Si logramos un nuevo antibiótico, que es algo que puede ocurrir dentro de 20 años, no podemos tener resistencias desde el primer día”, alerta Marín. La experta menciona dos medidas clave: prohibir la venta de antibióticos sin prescripción médica y acabar con su uso sistemático para estimular el crecimiento de animales sanos. Son dos políticas en vigor en la UE, pero inimaginables en los países más pobres, sin acceso a médicos y con necesidad de aumentar su producción de carne.
Cristina Muñoz defiende que España es un ejemplo para el mundo. Era el país con el máximo consumo de antibióticos de la UE en 2014, cuando arrancó el Plan Nacional. Desde entonces, según sus cifras, las ventas han caído un 33% en medicina humana y un 59% en veterinaria, a menudo gracias a acuerdos voluntarios con las empresas ganaderas. El mayor éxito es la reducción de prácticamente el 100% en el uso en los cerdos de colistina, un antibiótico descubierto en 1947 que se descartó para los humanos por su toxicidad renal y se reservó para la veterinaria.
Hace 15 años, ante la falta de alternativas, los médicos tuvieron que resucitar la colistina para usarla como último recurso en personas con infecciones multirresistentes, según recuerda Bruno González Zorn. “Esto da una idea de la situación en la que estamos. Estamos rescatando antibióticos tóxicos de los años cincuenta para salvar vidas en los hospitales del mundo. Es inaudito”, explica el microbiólogo. En noviembre de 2015, en China, se detectó por primera vez un gen capaz de convertir las bacterias en superbacterias resistentes a la colistina. Se abrió la caja de Pandora.